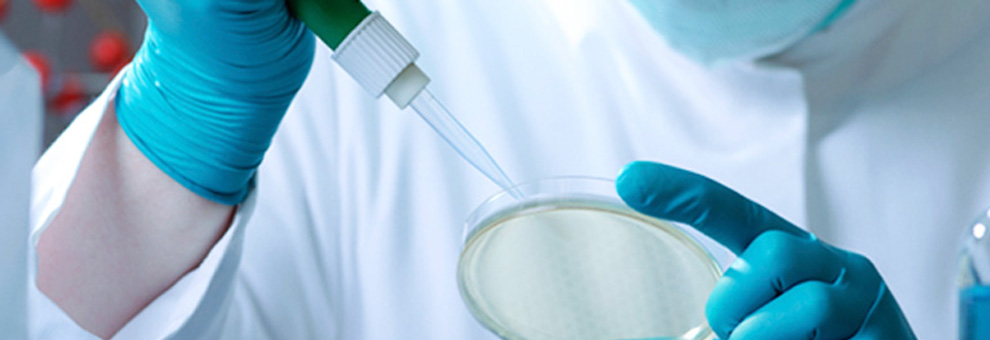

+91 98452 75111
Welcome TO Foray Life Care
The driving force at Foray Life Care is the sense of commitment that makes us offer qualitative and cost-effective medicines to prevent and treat some of the most serious illnesses prevalent in the world. Sweeping changes in public health have transformed life over the past century diversified to be a strong contender in the pharma space.
Foray Life Care entering the fast growing export market and catering to countries in Africa, South America, Europe and S. E Asia. We are now poised to manufacture and introduce our own brands into the global and domestic market.
Foray Life Care News
© Copyright 2012, Foray Life Care. All Rights Reserved.